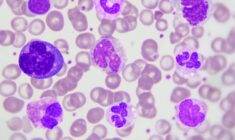
Bazofil düşüklüğü
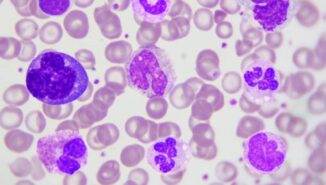
Bazofil düşüklüğü

Başlıklar
Monosit nedir?
Monosit, kemik iliğinden üretilen beyaz kan hücrelerinin (lökositlerin) tiplerinden birisidir. Kısaca MON şeklinde de ifade edilir. Boyut olarak en büyük beyaz kan hücresi tipidir. Beyaz kan hücrelerinin yaklaşık %10’unu oluşturan monositler kan dolaşımımıza ve diğer doku ve organlarımıza salınarak vücudumuzda bize bağışıklık sağlamakla görevlidir.
Virüs, bakteri ya da mantar gibi tüm yabancı ve zararlı mikroorganizmalar ile savaşır ve bizi hastalıklardan korunaklı kılar. Vücuda mikroorganizmalar girdiğinde o mikroorganizmaların girdiği yöne doğru hücum eder ve vücutta üreyip yayılmaya başlamadan önce mümkün olduğunca hızlı bir şekilde onları öldürüp yutarak vücuttan temizlemeye çalışır. Ayrıca bağışıklık yanıtının da arttırılmasını sağlar. Böylelikle vücut enfeksiyondan korunmuş olur.
Monosit yüksekliği
Beyaz kan hücrelerinden birisi olan monositlerin kemik iliğinde gereğinden fazla üretilmesi neticesinde monosit yüksekliği oluşur. Buna kısaca monositoz denilmektedir. Monositler, tüm lökosit hücrelerinin %1,7-9,3’ünü oluşturur. %10’un üzerine çıkan değer, monosit yüksekliğini ifade eder.
Monositlerin asıl amacı vücudu yabancı mikroorganizmalara karşı korumaktır; ancak eğer kemik iliği bir mutasyon geçirmişse üreteceği monositler genetik kusurlu olacaktır. Bu kusur neticesinde monositler kendi vücut hücrelerine saldırı yapabilir ya da tam randımanlı çalışamadığı için görevlerini aksatabilir. Bunun neticesinde artrit (eklem iltihabı), ateroskleroz (damar sertliği) gibi ciddi hastalıklar oluşabilir.
Monosit yükseklği ilk önce bir enfeksiyon veya iltihaplı bir hastalığı düşündürür. Acilen tetkik edilmesi gereken bir durumdur; çünkü kanserleşmeler de monosit yüksekliğine sebep olmaktadır. Monositler iltihap, enfeksiyon ve kanserli hücrelerle savaşabilmek için sayılarını arttırırlar ve kanda çoğalırlar. Bir diğer ihtimal ise herhangi bir sorundan kaynaklı olarak monositlerin yeterli çalışmaması ve kemik iliğinin mecburen daha fazla monosit üreterek açığı kapatmaya çalışması neticesinde kanda monositlerin çoğalmasıdır.
Monosit yüksekliği sebepleri
Monısitoz sebebi olan bazı hastalıklar ve durumlar şunlardır:
- Enfeksiyonlu hastalıklar ( Maya, bakteri ya da parazit kaynaklı enfeksiyonlar, akciğer enfeksyonları gibi)
- Ateşli hastalıklar
- Dolaşım sistemi hastalıkları (Kardiyovasküler hastalıklar)
- İltihaplı eklem romatizması (Romatoid artrit)
- Akciğer hastalıkları (Zatürre ya da verem hastalığı gibi…)
- Obezite (Organların fonksiyonlarını bozan bir durumdur.)
- Bağırsak hastalıkları (Örneğin; huzursuz bağırsak sendromu)
- Tüm kanser hastalıkları (Lösemi, lenf kanseri, akciğer kanseri, kolon kanseri vs…)
- Bağışıklığın hatalı çalışmasına sebep olan hastalıklar (Sarkoidoz, lupus gibi…)
- Böbrek üstü bezi hastalıkları
Monosit düşüklüğü
Monositopeni olarak da ifade edilen monosit düşüklüğü aslında sağlıklı kişilerde de görülebilir ve başka bulgulara rastlanılmadığı sürece normal kabul edilir. Bununla birlikte bir sorunu da işaret edebilir. Kemik iliğinde yetmezlik ya da kanserleşme oluşması monosit üretimini baskılayabilir ve monositopeni yaşanabilir. Bağışıklığı ya da kemik iliğinin kan hücresi üretimini baskılayıcı ilaçların çok sık kullanılması da buna sebep olmaktadır.
Monosit düşüklüğü sebebi olan bazı hastalıklar ve durumlar şu şekilde sıralanabilir:
- Stres (Bu daha ziyade tetikleyici bir faktördür. Eğer monosit düşüklüğüne sebep olan bir hastalığa yatkınlık varsa ya da bu hastalık vücutta hissettirmeden ilerliyorsa, stres bu sürecin hızlanmasına sebep olur.)
- Kansızlık (Anemi)
- B12 vitamini eksikliği (Sinir sisteminin iyi çalışmasını sağlayan bir vitamin çeşididir. Kemik iliğinin kan hücresi üretme mekanizması, merkezi sinir sistemi tarafından uyarılır. Bu uyarının güçlü alınabilmesi için B12 vitaminini yeterli tüketmek gerekir.)
- Lösemi (Kan kanseri anlamına gelir. Daha detaylı bilgi için “lösemi nedir“ isimli makalemizi okuyabilirsiniz.)
- Virüs kaynaklı enfeksiyonlar (Özellikle akut şekilde ilerleyen enfeksiyonlar bunda etkendir.)
- Tüberküloz (Çağımızda çok sık rastlanmasa da verem de monosit düşüklüğü sebepleri arasında sayılmaktadır.)
- İltihaplı eklem romatizması (Romatoid artrit)
- Lupus (Bağışıklık sisteminin hatalı çalışarak kendi vücut dokusuna zarar vermesi sonucu doku ve organlarda iltihaplar oluşturması şeklinde tanımlanan bir hastalıktır. Yüzde kelebek şekilli kırmızı döküntülere sebep olduğundan bu hastalığa “Kelebek Hastalığı” da denmektedir.)
- Cinsel yol ile bulaşan hastalıklar (AIDS, Hepatit gibi bağışıklık zafiyeti oluşturan hastalıklar buna örnek olarak verilebilir.)
- Kök hücrelere zarar veren kalıtsal hastalıklar
- Toksik etkiye sebep olan ilaçlara maruz kalmak (Örneğin tarım ilacı…)
- Antibiyotik, kemoterapi, radyoterapi gibi vücut hücrelerini yıkıma uğratan tedaviler almak
- Bir önceki yazımızda Lösantede hasta ve ailesinin sorumlulukları konusunu ele almıştık. Okumak için Lösantede hasta ve ailesinin sorumlulukları yazısını okuyabilirsiniz.
- Bir sonraki yazımızda ise, Hemoglobin konusundan bahsettik. Okumak için Hemoglobin nedir yazısını okuyabilirsiniz.